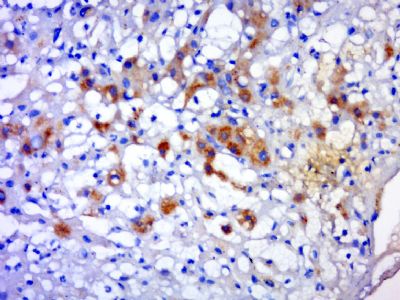
产品细节图片2

相关产品推荐更多 >
万千商家帮你免费找货
0 人在求购买到急需产品
- 详细信息
- 文献和实验
- 技术资料
- 供应商:
上海联迈生物工程有限公司
- 库存:
大量
- 目录编号:
LM-9229R
- 克隆性:
多克隆
- 抗原来源:
Rabbit
- 保质期:
1年
- 抗体英文名:
RNF156
- 抗体名:
环指蛋白156抗体
- 宿主:
Rabbit
- 适应物种:
Human, Mouse, Rat, Chicken, Dog, Pig, Cow, Horse, Rabbit, Sheep,
- 免疫原:
KLH conjugated synthetic peptide derived from human RNF156:201-300/552
- 亚型:
IgG
- 形态:
Lyophilized or Liquid
- 应用范围:
WB=1:500-2000 ELISA=1:500-1000 IHC-P=1:400-800 IHC-F=1:400-800 IF=1:50-200 (石蜡切片需做抗原修复)
- 浓度:
1mg/ml
- 保存条件:
Store at -20 °C
- 规格:
100ul 200ul
| 英文名称 | RNF156 |
| 中文名称 | 环指蛋白156抗体 |
| 别 名 | E3 ubiquitin-protein ligase MGRN1; KIAA0544; Mahogunin ring finger 1; Mahogunin RING finger protein 1; MGRN 1; MGRN1; MGRN1_HUMAN; Probable E3 ubiquitin protein ligase MGRN1; RING finger protein 156; RNF 156. |
| 规格价格 | 100ul/1380元 购买 200ul/2200元 购买 大包装/询价 |
| 说 明 书 | 100ul 200ul |
| 研究领域 | 细胞生物 免疫学 |
| 抗体来源 | Rabbit |
| 克隆类型 | Polyclonal |
| 交叉反应 | Human, Mouse, Rat, Chicken, Dog, Pig, Cow, Horse, Rabbit, Sheep, |
| 产品应用 | WB=1:500-2000 ELISA=1:500-1000 IHC-P=1:400-800 IHC-F=1:400-800 IF=1:50-200 (石蜡切片需做抗原修复) not yet tested in other applications. optimal dilutions/concentrations should be determined by the end user. |
| 分 子 量 | 61kDa |
| 细胞定位 | 细胞浆 细胞膜 |
| 性 状 | Lyophilized or Liquid |
| 浓 度 | 1mg/ml |
| 免 疫 原 | KLH conjugated synthetic peptide derived from human RNF156:201-300/552 |
| 亚 型 | IgG |
| 纯化方法 | affinity purified by Protein A |
| 储 存 液 | 0.01M TBS(pH7.4) with 1% BSA, 0.03% Proclin300 and 50% Glycerol. |
| 保存条件 | Store at -20 °C for one year. Avoid repeated freeze/thaw cycles. The lyophilized antibody is stable at room temperature for at least one month and for greater than a year when kept at -20°C. When reconstituted in sterile pH 7.4 0.01M PBS or diluent of antibody the antibody is stable for at least two weeks at 2-4 °C. |
| PubMed | PubMed |
| 产品介绍 | background: E3 ubiquitin-protein ligase. Mediates monoubiquitination at multiple sites of TSG101 in the presence of UBE2D1, but not of UBE2G1, nor UBE2H. Plays a role in the regulation of endosome-to-lysosome trafficking. Impairs MC1R- and MC4R-signaling by competing with GNAS-binding to MCRs and inhibiting agonist-induced cAMP production. Does not inhibit ADRB2-signaling. Does not promote MC1R ubiquitination. Function: E3 ubiquitin-protein ligase. Mediates monoubiquitination at multiple sites of TSG101 in the presence of UBE2D1, but not of UBE2G1, nor UBE2H. Plays a role in the regulation of endosome-to-lysosome trafficking. Impairs MC1R- and MC4R-signaling by competing with GNAS-binding to MCRs and inhibiting agonist-induced cAMP production. Does not inhibit ADRB2-signaling. Does not promote MC1R ubiquitination. Subunit: Interacts with MC1R and MC4R, but not with TBXA2R. Interacts with TSG101. Interacts with mislocalized cytosolically exposed PRNP; this interaction alters MGRN1 subcellular location and causes lysosomal enlargement (By similarity). Subcellular Location: Cytoplasm. Cell membrane. Post-translational modifications: Autoubiquitinated in vitro (By similarity). Similarity: Contains 1 RING-type zinc finger. SWISS: O60291 Gene ID: 23295 Database links: Entrez Gene: 23295 Human Entrez Gene: 17237 Mouse Entrez Gene: 302938 Rat Omim: 607559 Human SwissProt: O60291 Human SwissProt: Q9D074 Mouse SwissProt: Q5XIQ4 Rat Unigene: 526494 Human Unigene: 291326 Mouse Unigene: 15530 Rat Important Note: This product as supplied is intended for research use only, not for use in human, therapeutic or diagnostic applications. |
| 产品图片 | ![]() Paraformaldehyde-fixed, paraffin embedded (mouse stomach); Antigen retrieval by boiling in sodium citrate buffer (pH6.0) for 15min; Block endogenous peroxidase by 3% hydrogen peroxide for 20 minutes; Blocking buffer (normal goat serum) at 37°C for 30min; Antibody incubation with (RNF156) Polyclonal Antibody, Unconjugated (bs-9229R) at 1:400 overnight at 4°C, followed by a conjugated secondary (sp-0023) for 20 minutes and DAB staining ![]() Paraformaldehyde-fixed, paraffin embedded (Human hepatocellular carcinoma); Antigen retrieval by boiling in sodium citrate buffer (pH6.0) for 15min; Block endogenous peroxidase by 3% hydrogen peroxide for 20 minutes; Blocking buffer (normal goat serum) at 37°C for 30min; Antibody incubation with (RNF156) Polyclonal Antibody, Unconjugated (bs-9229R) at 1:400 overnight at 4°C, followed by a conjugated secondary (sp-0023) for 20 minutes and DAB staining |
风险提示:丁香通仅作为第三方平台,为商家信息发布提供平台空间。用户咨询产品时请注意保护个人信息及财产安全,合理判断,谨慎选购商品,商家和用户对交易行为负责。对于医疗器械类产品,请先查证核实企业经营资质和医疗器械产品注册证情况。
文献和实验Il-8是一种分子量为8~10kD的多肽,对嗜中性粒细胞,T淋巴细胞、嗜硷性粒细胞具有趋化作用,并可激活嗜中性粒细胞,是一种重要的炎症介质。在严重感染病人的血清中、炎症局部渗出液中都可检测到高水平的IL-8.此外,近年来的研究表明,IL-8可能与各种组织缺血后再灌注损伤的发生有关。我们采用两株自制的单克隆抗体建立了夹心法ELISA用于检测IL-8,敏感性可达156Pg/ml,操作简单,重复性良好,可用于IL-8的基础和临床研究。一、原理采用两株识别不同表位的抗IL-8单克隆抗体,其中一株(4D
相关专题 ELISA免疫实验技术 Il-8是一种分子 量为8~10kD的多肽,对嗜中性粒细胞,T淋巴细胞、嗜硷性粒细胞具有趋化作用,并可激活嗜中性粒细胞,是一种重要的炎症介质。在严重感染病人的血清中、炎症局部渗出液中都可检测到高水平的IL-8。此外,近年来的研究表明,IL-8可能与各种组织缺血后再灌注损伤的发生有关。我们采用两株自制的单克隆抗体建立了夹心法ELISA用于检测IL-8,敏感性可达156Pg/ml,操作简单,重复性良好
胰腺上皮内瘤变和胰腺癌组织中TGF-f3/Smad信号通路相关蛋白表达
分析,阐明胰腺癌的发病机制。1 材料与方法 1.1 病例资料 收集2001年1月~2003年12月第二军医大学附属长海医院病理科资料较完整的手术切除及同期尸检胰腺标本计250例。复读全部病理切片,根据PanlN最新概念和诊断标准,检出切片中全部PanlN病灶,共计351灶,分布于156例中。这156例包括导管腺癌121例、慢性胰腺炎23例,正常胰腺12例。其中,男性93例,女性63例,年龄3O~8O岁,平均58.6岁。121例胰腺导管腺癌中,发生于胰头部的有92例,胰体尾的27例,全胰的为2例
技术资料暂无技术资料 索取技术资料